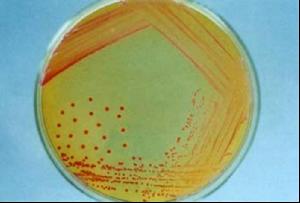
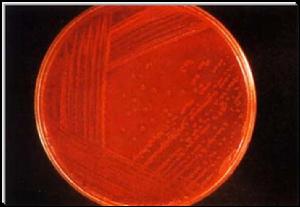

基本概述
假結核耶爾森菌 ( Yersinia pseudotuberculosis ) 屬於腸桿菌科耶爾森菌屬 ,是該菌屬三種致病性菌之一 ( 另兩種為鼠疫耶 爾 森 菌 ( Yersinia pestis ) 與 小 腸 結 腸 炎 耶 爾 森 菌( Yersinia enterocolitica) ) 。假結核耶爾森菌是一種人獸共患的腸道病原菌 ,流行病學特點與小腸結腸炎耶爾森菌很相似 ,但假結核耶爾森菌能夠感染的動物種類更廣泛 ,但感染率則低於小腸結腸炎耶爾森。假結核耶爾森菌感染在人群中以散發為主 ,偶爾也會引起不同規模的暴發。該菌可在低溫環境下生存 ,冰櫃貯存食物是現代社會發生該菌感染的一個重要傳染源 。
假結核耶爾森菌病是
一種食源性感染 ,一般僅是胃腸道症狀 、腸系膜淋巴結炎等 。但是由於其症狀不典型 ,極易造成診斷不明而延誤治療 ,導致發生腸外多種自身免疫性併發症 ,如關節炎 、虹膜炎 、間質性腎炎等 ,遷延不愈 ,影響病人的生活質量。
傳播與治病
小腸結腸炎耶爾森菌廣泛分布於自然界,是能在冷藏溫度下生長的少數幾種腸道致病菌之一。本菌天然寄居在多種動物體內,如豬、鼠、家畜等,通過污染食物(牛奶、豬肉等)和水經糞—口途徑感染或因接觸染疫動物而感染。它除引起胃腸道症狀外,還能引起呼吸系統、心血管系統、骨骼結締組織等疾患,甚至可引起敗血症,造成死亡。該菌還是重要的食源性致病菌,很多國家都已將該菌列為進出口食品的常規檢測項目。
臨床醫生在對胃腸道疾病診斷時很少考慮小腸結腸炎耶爾森菌感染,檢驗人員也很少能為準確診斷提供依據。由於診斷不及時,容易造成誤診,多數小腸結腸炎耶爾森菌感染病人很難得到及時、針對性治療,造成感染慢性化和並發各種合併症,有些小腸結腸炎耶爾森菌感染甚至被當作闌尾炎施行手術。
細菌的生物學特性
小腸結腸炎耶爾森菌腸桿菌科耶爾森菌屬,為革蘭氏陰性小桿菌,有毒菌株多呈球桿狀,無毒株以桿狀多見。對營養要求不高,能在麥康凱瓊脂上生長,但較其他腸道桿菌生長緩慢,培養的最適宜溫度為28℃,最適pH值為7~8,初次培養菌落為光滑型,通過傳代接種後菌落可能呈粗糙型。
本菌具有“嗜冷性”,在水中和低溫下(4℃)能生長,為腸道中能在4℃生長繁殖的少數細菌之一。因此,食品冷藏保存時,應防止被該菌污染。
野生動物、家畜(豬、狗和貓)、牡蠣和水源中都能分離到本菌,亦可從健康人或患者糞便中分離得到,其傳播方式可能與攝入被尿、糞便污染的食物(尤其是肉類)和接觸感染動物等有關。
本菌可產生耐熱腸毒素,121℃30分鐘不被破壞,對酸鹼穩定,pH1~11不失活。腸毒素產生迅速,在25℃下培養12小時,培養基上清液中即有腸毒素產生,24~48小時達高峰。腸毒素是引起腹瀉的主要因素。毒力型菌株均有VW抗原(蛋白脂蛋白複合物),為毒力的重要因子,與侵襲力有關,侵襲力可能是耶爾森菌感染腸道表現的病理基礎。

小腸結腸炎耶爾森菌的革蘭氏染色細菌的防治
症狀較輕時,本病多為自限性,無需抗菌治療。宜進行適當隔離,糞便及排泄
物要消毒,以免疾病傳播。有失水者及時補液,以糾正水、電解質、酸鹼紊亂。對病程較長,有併發症或呈暴髮型者,應給予抗菌治療。本菌對所有氨基糖甙抗生素、
多粘菌素、複方新諾明、四環素、呋喃唑酮和喹諾酮類等均敏感。
細菌的生物安全防護
根據《病原微生物生物實驗室生物安全管理條例》中的有關規定,人間傳播的微生物名錄(待頒布)小腸結腸炎耶爾森菌屬於三類,BSL-2.相關的防護事宜包括:
(1)操作要求
1、實驗時,未經實驗室主任同意,限制或禁止進入實驗室。
2、不許在工作區域飲食、吸菸、清洗隱型眼鏡和化妝。食物應存放在工作區域以外專用櫥櫃或冰櫃中。
3、所有的操作過程應儘量細心,避免產生和濺出氣溶膠。
4、對於污染的銳器,必須時刻保持高度的警惕,包括針、注射器、玻片、加樣器等。
5、注射和吸取感染材料時,只能使用針頭固定注射器或一次性注射器(即注射器和針頭是一體的)。用過的一次性針頭必須彎曲、切斷、破碎、重新套上針頭套、從一次性注射器上去掉,或在丟棄前進行人工處理,要不將之小心放入不會被刺穿的、用於收集廢棄銳器的容器中。非一次性銳器必須放置在堅壁容器中,轉移至處理區消毒,最好高壓殺菌。
6、打碎的器皿不能直接用手處理,必須用其它工具處理,如刷子和簸箕、夾子或鑷
7、所有的培養物、儲存物及其它規定的廢物在釋放前,均應使用可行的消毒方法進行消毒,如高壓滅菌。轉移到就近實驗室消毒的物料應置於耐用、防漏容器內,密封運出實驗室。離開該系統進行消毒的物料,在轉移前應包裝,其包裝應符合有關的法規。
8、濺出或偶然事件中,明顯暴露於傳染源時,要立即向實驗室主任報告。進行適當的醫學評估、觀察、治療,保留書面記錄。
9、按日常程式、在有關傳染源的工作結束後、尤其是傳染源濺出或灑出後、或受到其他傳染源污染後,實驗室設備和工作檯面應當使用有效的消毒劑消毒。污染的設備在送去修理、維護前,要按照相關的規定消毒;在離開設施轉移前,要按照相關的規定打包運輸。
